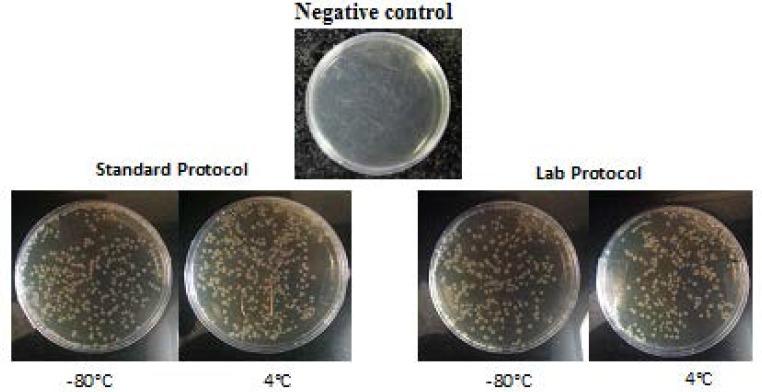

热休克步骤对细菌转化效率的影响。
Impact of heat shock step on bacterial transformation efficiency.
作者信息
Rahimzadeh Maral, Sadeghizadeh Majid, Najafi Farhood, Arab Seyed, Mobasheri Hamid
机构信息
Department of Nanobiotechnology, School of Biological Sciences, Tarbiat Modares University, Tehran, Iran.
Department of Molecular Genetics, School of Biological Sciences, Tarbiat Modares University, Tehran, Iran.
出版信息
Mol Biol Res Commun. 2016 Dec;5(4):257-261.
CaCl treatment followed by heat shock is the most common method for artificial transformation. Here, the cells were transformed using CaCl treatment either with heat shock (standard protocol) or without heat shock (lab protocol) to comprehend the difference in transformation efficiency. The BL21 strain of () was being susceptible using CaCl treatment. Some Cells were kept at -80 C while the others were kept at 4 ˚C. Afterwards the susceptible cells were transformed using either standard or lab protocol. The transformation efficiency between cells experienced heat shock and those were not influenced by heat shock was almost the same. Moreover, regardless of transformation protocol, the cells kept at 4 ˚C were transformed more efficiently in compared to those were kept at -80 C.
氯化钙处理后进行热休克是人工转化最常用的方法。在这里,使用氯化钙处理对细胞进行转化,分别采用热休克(标准方案)或不采用热休克(实验室方案),以了解转化效率的差异。(此处括号内容缺失)的BL21菌株对氯化钙处理敏感。一些细胞保存在-80℃,而另一些保存在4℃。之后,使用标准或实验室方案对敏感细胞进行转化。经历热休克的细胞和未受热休克影响的细胞之间的转化效率几乎相同。此外,无论转化方案如何,保存在4℃的细胞比保存在-80℃的细胞转化效率更高。